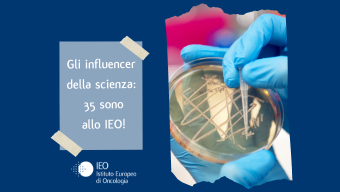

News dallo IEO
-
Filtra per Categoria
-

Pubblicato il: 10 giugno 2024
Il 5x1000 arriva in città, in un luogo insolito: l’edicola!
Vi aspettiamo fino al 14 giugno
-

Pubblicato il: 12 giugno 2024
Giuseppe Curigliano, nuovo Presidente dell’ESMO per il biennio 2027-2028
Il Prof. Giuseppe Curigliano è il IV presidente italiano dell'ESMO in quasi 50 anni di storia
-

Pubblicato il: 13 giugno 2024
Operazione ASPIC: una cena speciale dà il via a un progetto dedicato ai pazienti con disfagia
-

Pubblicato il: 13 febbraio 2025
Avviso di sciopero
13/02/2025 – Causa sciopero, possibili ritardi nell’erogazione delle prestazioni ospedaliere
-

Pubblicato il: 21 maggio 2024
XXIII edizione della Giornata Nazionale del Sollievo
Lunedì 27 maggio lo IEO celebra la Giornata del Sollievo con una serata speciale a Seregno
-

Pubblicato il: 17 maggio 2024
Giovedì 30 maggio, Settimana Mondiale della Tiroide: screening gratuiti allo IEO
-

Pubblicato il: 14 maggio 2024
Settimana Mondiale per la Riduzione del Consumo di Sale: IEO aderisce alla campagna “MENO SALE PER TUTTI”
-

Pubblicato il: 07 maggio 2024
Melanoma May
Il 17 maggio, alle ore 10.00, vi aspettiamo al Melanoma May, un'iniziativa gratuita e aperta a tutti sul tema del melanoma.
-

Pubblicato il: 17 aprile 2024
IEO Book Club
16 maggio ore 18.00 – secondo incontro IEO Book Club con Donato Carrisi
-

Pubblicato il: 02 maggio 2024
Il Power Registry arriva in IEO
Un registro per i pazienti trattati con la Protonterapia
-

Pubblicato il: 12 maggio 2024
12 maggio 2024 - Giornata Internazionale dell’Infermiere
Allo IEO e al Monzino si celebra la Giornata Internazionale dell'Infermiere
-

Pubblicato il: 08 maggio 2024
Domenica 12 maggio, Festa della Mamma: L’Azalea della Ricerca di Fondazione AIRC compie quarant’anni
-

Pubblicato il: 03 maggio 2024
Intervista alla Dott.ssa Paola Queirolo
La Dott.ssa ha offerto una panoramica sul melanoma nel corso di un'intervista su RAI2 TG2 Medicina 33
-

Pubblicato il: 22 aprile 2024
TUMORI DEL RETTO: EVITARE LA CHIRURGIA È POSSIBILE
In IEO incontro regionale della Società Italiana di Chirurgia (SIC) sulle ultime frontiere della cura del tumore del retto.
-

Pubblicato il: 18 aprile 2024
Protocollo di Intesa tra IEO e l’Accademia del Paziente Esperto EUPATI
Attività educative per promuovere l’empowerment dei pazienti
-

Pubblicato il: 08 aprile 2024
EVENTI GRATUITI DEDICATI ALLA SALUTE DELLA DONNA
Open week sulla salute della donna
-

Pubblicato il: 25 marzo 2024
Tumore al seno. Il più diffuso, ma su cui si investe troppo poco.
Il contributo dell’Italia nella ricerca e l’importanza della prevenzione.
-

Pubblicato il: 21 marzo 2024
Vaccini e nuove terapie contro il melanoma: scopriamo di più
Intervista con la dott.ssa Paola Queirolo
-

Pubblicato il: 20 giugno 2023
Dopo le cure, la miglior qualità di vita possibile
La misurazione dei risultati clinici e della qualità della vita dopo le cure: fattore fondamentale per il benessere dei pazienti
-

Pubblicato il: 19 dicembre 2023
Allo IEO un nuovo pace-maker contro il dolore
Il neurostimolatore Inceptiv intercetta e contrasta gli impulsi che fanno percepire il dolore
-

Pubblicato il: 14 marzo 2024
STUDIO ACCLAIM, IEO primo centro arruolatore in Italia
Lo IEO è la prima struttura in Italia a ottenere il via libera dalla SIO.
-

Pubblicato il: 29 novembre 2023
Si cura meglio con i protoni
IEO Proton Center apre le porte ai pazienti
-

Pubblicato il: 22 gennaio 2024
RƏvolution: il primo meeting su Social Media e Digitalizzazione in Medicina
Appuntamento in IEO il 26 gennaio. Fra gli ospiti Daria Bignardi e Pegah Moshir Pour
-

Pubblicato il: 24 gennaio 2024
Le Arance della Salute di AIRC
Il 27 gennaio nelle piazze del nostro Paese
-

Pubblicato il: 14 novembre 2023
In IEO arriva Confirmo, un nuovo strumento per la firma elettronica dei pazienti
-

Pubblicato il: 24 novembre 2023
IEO definisce nuovi standard per valutare la qualità delle cure in oncologia
Agenas (Agenzia nazionale per i servizi sanitari regionali) e Sics (Società italiana di Comunicazione Scientifica e Sanitaria) premiano il nostro Istituto per l’innovazione in Sanità digitale
-

Pubblicato il: 10 novembre 2023
Tumore del polmone: una sfida da affrontare insieme
Vi aspettiamo il 21 novembre, alle ore 13.00, in diretta sulla nostra pagina Facebook!
-

Pubblicato il: 09 novembre 2023
HIGHLIGHTS ESMO2023
Polmone, seno, ginecologia, tumori dell'apparato digerente e neuroendocrini e psiconcologia: le novità dell'ultimo congresso direttamente dalla voce dei protagonisti delle ricerche
-

Pubblicato il: 14 novembre 2023
La violenza psicologica della malattia
Webinar aperto a tutte le pazienti
-

Pubblicato il: 18 ottobre 2023
IEO SECOND OPINION
Il servizio a distanza per ricevere indicazioni riguardo a una diagnosi già ricevuta
-
Pubblicato il: 06 novembre 2023
Nuova classifica degli influencer della scienza: 35 sono allo IEO
Pubblicati dalla Standford University i nomi dei ricercatori più citati al mondo nel 2022
-

Pubblicato il: 31 ottobre 2023
Prenditi cura di te con IEO Cosmetica!
Il 6 novembre IEO Cosmetica regala una seduta dermocosmetica in Istituto
-

Pubblicato il: 30 ottobre 2023
La riabilitazione dopo il trattamento del tumore della mammella
Due giornate di corso per fisioterapisti
-

Pubblicato il: 25 ottobre 2023
II° Giornata della Ricerca - L’evoluzione della Qualità nella Ricerca Clinica
Appuntamento in IEO per il 13 dicembre
-

Pubblicato il: 23 ottobre 2023
Carcinoma gastrico: buone notizie dal workshop IEO sulla cura multidisciplinare
Fazio e Fumagalli Romario promotori dell'iniziativa
-

Pubblicato il: 23 ottobre 2023
BRA DAY
Una donna informata è una donna consapevole delle proprie scelte. Gli specialisti IEO rispondono!
-

Pubblicato il: 19 ottobre 2023
Lo IEO nelle Top 100 aziende sostenibili italiane
Il nostro Istituto ha ricevuto il Sustainability Award
-

Pubblicato il: 16 ottobre 2023
AMMI Donne per la salute, premio a Paola Zagami
La Dottoressa vince con un progetto su Medicina e Farmacologia di Genere
-

Pubblicato il: 12 ottobre 2023
Premio alla Carriera della Società Europea di Ginecologia Oncologica (ESGO) alla Prof.ssa Colombo
Riconoscimento consegnato ad Istanbul durante il Congresso Annuale ESGO
-

Pubblicato il: 12 ottobre 2023
Parliamo di tiroide. Il nostro team di Specialisti risponde!
Vi aspettiamo il 12 Ottobre, alle ore 17.00, in diretta sul nostro canale Facebook!
-

Pubblicato il: 26 luglio 2023
Ecografie mammarie (primi accessi e controlli)
Nuovi spazi disponibili
-

Pubblicato il: 03 ottobre 2023
Il Case Management intraospedaliero nel percorso di presa in carico del paziente oncologico
Appuntamento in IEO il 15, 16 e 17 novembre
-

Pubblicato il: 26 settembre 2023
Let's Talk about cancer.
Dalle domande delle pazienti alle risposte degli oncologi.
-

Pubblicato il: 22 settembre 2023
IEO COSMETICA PARTECIPA ALLA MILANO BEAUTY WEEK!
ll 28 e il 29 settembre IEO Cosmetica sarà presente con uno stand a Palazzo Giureconsulti per offrire consulenze personalizzate con estetiste esperte.
-

Pubblicato il: 19 settembre 2023
AIRC con IEO per la prevenzione
Due giornate all’insegna della prevenzione



























